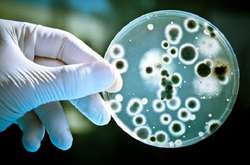
Киянин привіз із відпочинку лихоманку Західного Нілу

Що заважає впровадженню державної страхової медицини в Україні?

Страхова медицина в рази поліпшує якість медичного обслуговування і мінімізує фінансове навантаження на пацієнта в разі захворювання
Медична реформа нібито передбачає впровадження страхової медицини. Втім, тут виходить, як і в ситуації з реалізацією пенсійної реформи – введення задекларованого накопичувального рівня з 1 січня 2019 року лишається під загрозою через недопрацювання на законодавчому й адміністративному рівнях. Так і зі страховою медициною. З прийняттям законодавства щодо медичної реформи, керівництво МОЗ обіцяло її запуск з 2018 року. Проте, декларованої новації досі так і не відбулося.
Страхова медицина в рази поліпшує якість медичного обслуговування і мінімізує фінансове навантаження на пацієнта в разі як раптового, так і хронічного захворювання. Проте, всі дотеперішні спроби впровадження медичного страхування в Україні виявилися безплідними. Деякі експерти пояснюють це тим, що вітчизняна економіка неспроможна фінансово забезпечити дану модель. Але чому ми не можемо використати одну з успішних західних моделей (наприклад, США чи Великобританії), або перейняти кращі елементи з них – лише адаптувавши їх до українських економічних реалій?
Чи готовий бізнес додатково платити за страхову медицину?
Я недарма тут провожу аналогію з пенсійною реформою. Адже її другий етап передбачає додаткове навантаження на роботодавців і працівників – у сенсі сплати як мінімум ще 2 % від заробітної плати до соціального внеску, яке здебільшого сприймається як посилення фіскального тиску. Недовіра до пенсійної реформи як такої з боку суспільства й бізнесу часто призводить до відсутності у компаній мотивації, щоб працювати «по-білому». Звідси – міграція в «тінь», де податки й соціальні внески «оптимізуються» в рази. Як відомо, пропонована МОЗ модель страхової медицини передбачає ще більше навантаження на зарплатний фонд у формі додаткових відсотків, що нараховуються на зарплату працівників. А це – 4 % плюс до соціального внеску.
Чи готові психологічно до ще одного «зайвого» навантаження на зарплату роботодавці і наймані працівники – за умови, що у нас і так, за даними МВФ, 45 % економіки перебуває «в тіні»? І чи не отримаємо ми ще один гіпердефіцитний страховий медичний фонд? При тому, що один фонд – пенсійний – із дефіцитом у 145 млрд. грн. ми вже маємо.
Тобто, якщо бізнес оптимізує свої податкові і «пенсійні» видатки, то де гарантія, що він не оптимізуватиме медично-страхові відрахування? Скажімо, за економічними розрахунками моделі загальнообов’язкового медичного страхування, приватні компанії (включаючи ФОПів) мають заплатити до страхового фонду 21 млрд. грн., тоді як держава – 76 млрд. грн. З урахуванням того, що цьогорічний бюджет на медицину становить 86,9 млрд. (тобто розмір страхового фонду – це практично ще один річний медичний бюджет), а прогнози щодо виплат від бізнесу можуть бути занадто оптимістичними, швидкий запуск страхової медицини може виявитися передчасним, а то й узагалі – нереалістичним.
Отже, цю проблему держава має розглядати в тісному комплексі з економічними реформами, спрямованими на детінізацію економіки, лібералізацію податкової системи і трансформацію її з фіскальної на сервісну, спрощення адміністрування податків, введення наступних рівнів пенсійного страхування тощо. Лише тоді впровадження страхової медицини буде успішним, коли воно матиме бездоганне економічне обгрунтування і соціальний запит, а не сприйматиметься як збільшення тиску держави на бізнес і громадян у формі додаткового й немотивованого оброку.
Державне медстрахування відсутнє, приватне – малодоступне
Іще одне. За даними Всесвітньої Організації охорони здоров’я, для нормального функціонування української медицини потрібно 100 млрд. грн. з річного бюджету До речі, на думку експертів ВООЗ, 40 % цієї суми покривається за рахунок неформальних платежів. За задумом ініціаторів медичної реформи, держава на першому етапі оплачуватиме лише первинну допомогу в комунальних медзакладах та невідкладну й екстрену допомогу. Ті ж медичні послуги, які сюди не входять, пацієнт мусить оплачувати зі своєї кишені. Але чи працюватиме ефективно така система, чи захищатиме вона інтереси пацієнта – в умовах тотальної бідності й занепаду національної економіки? Наразі не є зрозумілим, коли саме розпочнеться імплементація державного медичного страхування, і коли за рахунок страхового фонду будуть оплачуватися медичні послуги пацієнтам на вищих щаблях лікування.
Хтось скаже, що люди можуть застрахувати своє здоров’я в приватних страхових компаніях? Втім, українці не поспішають купувати поліси добровільного медичного страхування (ДМС). За статистикою, сьогодні лише 5-6 % населення мають поліс ДМС. З одного боку, сам ринок медичного страхування знаходиться на початковому етапі розвитку; його до 2017 року гальмувала нереформована система охорони здоров’я. Але й зараз цей вид страхування розвивається здебільшого на корпоративному рівні. До того ж, послуги з індивідуального ДМС дорожче корпоративного в 4-5 разів, а самі умови обмежені великою кількістю винятків і лімітів на медикаменти. До того ж вартість індивідуального страхування коливається в межах 20-30 тисяч гривень. На жаль, переважна більшість наших громадян не може дозволити собі таку розкіш. Цілком природно, що зараз, за даними страховиків, 90 % всього ринку особистого страхування знаходиться в корпоративному секторі.
І що робити пересічному українцеві сьогодні, коли він раптом серйозно захворіє і йому буде вкрай необхідна термінова операція? На жаль, в наших умовах середньостатистичний пацієнт економічно не має змоги оплатити суму за високоякісну медичну послугу, яка вимірюється кількома десятками, а то і сотнями тисяч гривень. Сьогодні той же таки Фейсбук та інші соціальні мережі рясніють оголошеннями про збір коштів на термінове лікування дитини чи дорослої людини. Знову-таки, ці нагальні проблеми часто вирішуються за допомогою волонтерів і багатьох небайдужих людей. Але ж дуже часто, навіть їхніх зусиль і зібраних коштів не вистачає на лікування чи операцію. Держава в таких випадках – не тільки безсила, але й байдужа. Втім, у критичних випадках із складними захворюваннями дуже багато життів могло б бути врятовано, якби в нас працювало державне медичне страхування.
Компроміс в інтересах пацієнта
Україна, в рамках медичної реформи, відмовилася від принципу співоплати за медичні послуги, обравши класичну британську модель страхової медицини. Але цей концепт поки що діє лише на рівні первинної медичної допомоги. Звісна річ, сьогодні держбюджет не готовий виділити десятки додаткових мільярдів гривень для функціонування державного страхового фонду. Але ж хіба є неможливим – до повноцінного запуску системи медичного страхування – ввести на перехідному етапі хоча б співоплату на вторинні (далі – на третинні) медичні послуги, встановивши диферинційовані відсотки – залежно від градації захворювань за складністю як самої хвороби, так і технологій та методів її лікування?
Наприклад, можна було б створити «перехідний» (модельний) страховий фонд під дахом Національної служби здоров’я, який наповнювався б частково з держбюджету, частково – зі страхових внесків із заробітної плати. Це дозволило б ввести на першому етапі співфінансування принаймні мінімального переліку найбільш затребуваних в країні медичних послуг та хірургічних операцій, визначеного незалежною експертною радою при МОЗ. Разом з економічним зростанням, бюджетними спроможностями цей перелік мав би поступово поширюватися на більш складні, а отже й дорожчі лікувальні методи й медичні технології.
Однак, слід констатувати, що сьогодні в вищих політичних ешелонах, а також серед профільних громадських структур існує чимало противників впровадження страхової медицини – від популістів соціалістичного штибу, які спекулюють на темі «безкоштовної» медицини, до ультралібералів, котрі закликають перейти до повністю платної для громадян медицини і до майже тотального відсторонення держави від цієї надважливої сфери.
Як на мене, державні органи, що відповідають за впровадження медичної реформи, мали б розробити й реалізувати потужну медійну і соціально-рекламну кампанію, головна мета якої – пояснення суті, переваг для кожного українця державної страхової медицини, роз’яснення механізмів і стимулів як для роботодавців, так і для найманих працівників.
Кожен пацієнт повинен бачити особисту вигоду від впровадження державного медичного страхування, а топ-чиновники медичної, економічної і соціальної сфер мали б розглядати його як необхідний компонент поліпшення і зміцнення здоров’я нації, а відтак – зростання економічного потенціалу, а також переорієнтації місцевих медичних бюджетів з витрат на лікування хвороб – на профілактичну складову, створення оздоровчої та фізкультурної інфраструктури.
Модель страхової медицини є найбільш оптимальним компромісом поміж непродуктивними в економічному й соціальному сенсах крайнощами. В принципі, за умови її існування, кожен офіційно працюючий українець знатиме, що, по суті, він фінансує страхову медицину зі своїх внесків і податків. Але ці виплати будуть розтягнутими в часі і не «битимуть по кишені». Водночас, у разі несподіваної хвороби і необхідності коштовної операції, пацієнт може не хвилюватися про фінансування, яке здійснюватиметься зі страхового фонду. Звісна річ, людина працездатного віку, яка не платить внесків до страхового фонду, оплачуватиме лікування із власної кишені. Власне, це буде ще одним дієвим стимулом для виходу бізнесу з «тіні».
Втім, найболючішим питанням, що стоїть на порядку денному медичної реформи, є наступне: чи можлива в принципі ефективна й успішна державна модель страхової медицини – за умови панування олігархічної та корупційної економіки, яка наполовину перебуває в «тіньовому» безподатково-офшорному спектрі?

Коментарі — 0